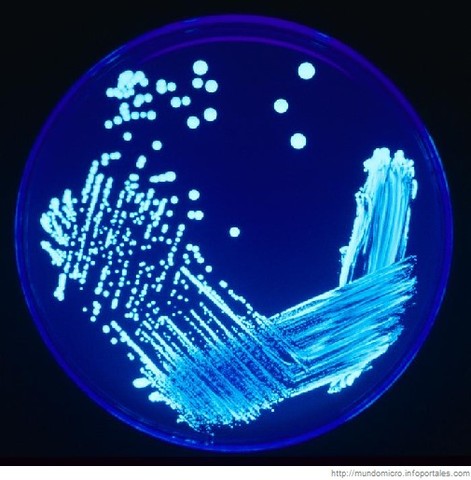
1977

-
Aristoteles especula sobre la naturaleza de la reproducción y herencia
-
Se confirmo la reproducción sexual de las plantas
-
Se contempla el esperma animal a través del microscopio
-
Se descubre que todos los organismos vivos están compuestos por células.
-
Darwin hace publica su teoría sobre la evolución de las especies.
-
Mendel descubre en los guisantes las unidades fundamentales de la herencia (Genes.)
-
Se aisla en ADN en el nucleo de una celula
-
Francis Galton acuña el termino eugenesia.
-
Se descubre que las células reproductivas constiittuyen un linaje continuo, diferente de las otras células del cuerpo.
-
Se descubre que las células reproductivas constituyen un linaje continuo, diferente a las otras células.
-
Las unidades fundamentales de la herencia biológica reciben el nombre de Genes
-
Se descubre que la actividad del gen esta relacionada con su posición en el cromosoma.
-
Se descubre que los Rayos X causan mutaciones genéticas.
-
El ADN es identificado como la molécula génica.
-
Se descubre que cada gen codifica una única proteína.
-
Se produce la estructura en doble Hélice del ADN
-
Son identificados 23 pares de cromosomas en las células del cuerpo humano
-
Se descifra el código genético completo del ADN.
-
Se crea la primera molécula de ADN recombinante en el laboratorio.
-
Tienen lugar los primeros experimentos de ingeniería genética en los que gentes de una especie se introducen en organismos de otra especie y funcionan correctamente.
-
Se obtienen por primera vez los hidromasajesibridomas que producen anticuerpos monoclonales.
-
Se fabrica con éxito la primera hormona humana en una bacteria.
-
Se clona el gen de la insulina humana.
-
Se crea el primer ratón transgenico, insertando el gen de la hormona del crecimiento de la rata en óvulos de ratona fecundados.
-
Creación de las primeras plantas transgenicas.
-
Primera patente de un organismo producido mediante ingeniería genética.
-
Primeras secuencias completas de genomas de organismos: se trata de las bacterias Haemophilus influenzae y Mycoplasma genitalium.
-
Por primera vez se completa la secuencia del genoma de un organismo eucariotico. (Levadura de cerveza).
-
Clonacion del primer mamífero, la oveja Dolly.
-
El proyecto genoma humano y Celera Genomics presentan el primer borrador de la secuencia del genoma humano.
-
Se completa con éxito el Proyecto Genoma Humano con el 99% del genoma secuenciado con una precisión del 99,99%
-
Se descubrió la interferencia por ARN: silenciamiento de genes por ARN de doble cadena.
-
Se descubrió los principios para introducir modificaciones génicas especificas en ratones mediante el uso de células troncales embrionarias.
-
descubrimiento de como son los cromosomas al ser protegidos por los telomeros y la enzima telomerasa.